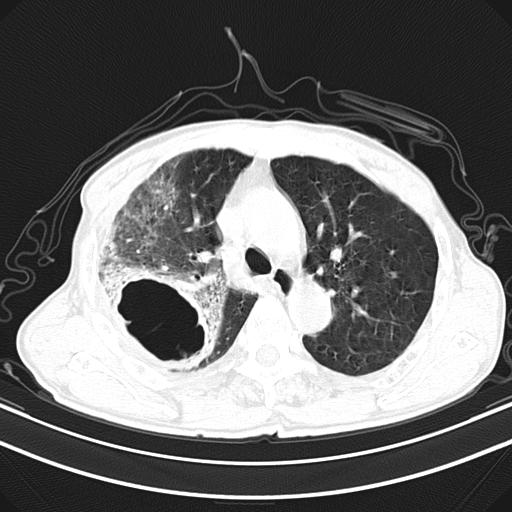

医影在线
标题: CT23873:男,70,发烧咳嗽咳痰10余天,查痰结核菌阴性 [打印本页]
作者: haitian598 时间: 2009-12-31 05:25
标题: CT23873:男,70,发烧咳嗽咳痰10余天,查痰结核菌阴性
男,70,发烧咳嗽咳痰10余天,查痰结核菌阴性。否认以前有肺病史。治疗10天后症状减轻。 img]/upload/forum/2009/12/302117469692.jpg[/img]

抗炎治疗10天后复查


















[本贴已被 haitian598 于 2009-12-30 21:28:21 修改过]
[本贴已被 haitian598 于 2009-12-30 21:31:20 修改过]
[本贴已被 jiajie 于 2009-12-31 7:59:21 修改过]
作者: zsl6918 时间: 2009-12-31 05:27
首先考虑结核空洞并感染
作者: 进修医生 时间: 2009-12-31 06:11
双肺多发斑片状条索样及网格状改变,右上肺可见大个空洞,首先考虑tb慢性炎症并空洞形成。
作者: 黑白光影 时间: 2009-12-31 06:56
同意
作者: agxsdrgyp 时间: 2009-12-31 07:54
支持
作者: 513ytb 时间: 2009-12-31 07:58
双肺多发斑片状条索样及网格状改变,右上肺可见大个空洞,首先考虑tb慢性炎症并空洞形成。特发行纤维化。肺癌待排。
作者: wufeisheng 时间: 2009-12-31 08:32
临床表现:急性病程,查痰结核菌阴性。
影像所见:右上肺见一巨大厚壁空洞,内壁欠光整,右上肺广泛斑片状、大片状模糊阴影。
抗炎治疗10天后复查:右上肺模糊阴影明显减少。
诊断意见:考虑右上肺巨大含气囊肿并感染,建议继续治疗后复查。
不支持点:空腔壁较厚,欠光滑。询问病人是否有反复感染病史?
结核临床及影像,结核暂不考虑。
作者: 守望可可 时间: 2009-12-31 08:55
标题: 回复:肺部病变
以下是引用wufeisheng在2009-12-31 0:32:00的发言:[br]临床表现:急性病程,查痰结核菌阴性。[br]影像所见:右上肺见一巨大厚壁空洞,内壁欠光整,右上肺广泛斑片状、大片状模糊阴影。[br]抗炎治疗10天后复查:右上肺模糊阴影明显减少。[br]诊断意见:考虑右上肺巨大含气囊肿并感染,建议继续治疗后复查。[br]不支持点:空腔壁较厚,欠光滑。询问病人是否有反复感染病史?[br]结核临床及影像,结核暂不考虑。[br]
有理!病灶跨叶、段分布,抗炎治疗明显好转,临床症状也支持,还应考虑肺脓肿的可能。建议楼主给纵隔窗,看下胸膜情况。
作者: yuhongjun 时间: 2009-12-31 13:21
标题: 回复:肺部病变
以下是引用wufeisheng在2009-12-31 0:32:00的发言:[br]临床表现:急性病程,查痰结核菌阴性。[br]影像所见:右上肺见一巨大厚壁空洞,内壁欠光整,右上肺广泛斑片状、大片状模糊阴影。[br]抗炎治疗10天后复查:右上肺模糊阴影明显减少。[br]诊断意见:考虑右上肺巨大含气囊肿并感染,建议继续治疗后复查。[br]不支持点:空腔壁较厚,欠光滑。询问病人是否有反复感染病史?[br]结核临床及影像,结核暂不考虑。[br]
作者: 卜一 时间: 2009-12-31 14:43
以下是引用wufeisheng在2009-12-31 0:32:00的发言:
临床表现:急性病程,查痰结核菌阴性。
影像所见:右上肺见一巨大厚壁空洞,内壁欠光整,右上肺广泛斑片状、大片状模糊阴影。
抗炎治疗10天后复查:右上肺模糊阴影明显减少。
诊断意见:考虑右上肺巨大含气囊肿并感染,建议继续治疗后复查。
不支持点:空腔壁较厚,欠光滑。询问病人是否有反复感染病史?
结核临床及影像,结核暂不考虑。
支持!
作者: zhengfaming 时间: 2009-12-31 16:09
临床表现:急性病程,查痰结核菌阴性。
影像所见:右上肺见一巨大厚壁空洞,并见分隔,内壁欠光整,右上肺广泛斑片状、大片状磨玻璃阴影。
抗炎治疗10天后复查:右上肺模糊阴影明显减少。
诊断意见:考虑右上肺巨大含气囊肿并感染,建议继续治疗后复查。
不支持点:空腔壁较厚,欠光滑。询问病人是否有反复感染病史?
结核临床及影像,结核暂不考虑(十天就明显减轻,不十分支持结核。)
作者: 随光逐影 时间: 2009-12-31 17:13
右肺感染性病变(右肺上叶肺脓肿?);建议:抗炎治疗后复查。
作者: zxl51642 时间: 2009-12-31 17:33
临床表现:急性病程,查痰结核菌阴性。
影像所见:右上肺见一巨大厚壁空洞,内壁欠光整,右上肺广泛斑片状、大片状模糊阴影。
抗炎治疗10天后复查:右上肺模糊阴影明显减少。
诊断意见:考虑右上肺巨大含气囊肿并感染,建议继续治疗后复查。
不支持点:空腔壁较厚,欠光滑。询问病人是否有反复感染病史?
结核临床及影像,结核暂不考虑。
作者: 北方的狼 时间: 2009-12-31 17:51
这例首先确定为感染性病变应该没问题,关键是怎么解释哪个大洞的问题。结核没有卫星病灶;脓肿没有液平;病毒感染?;真菌?;寄生虫?-----?
作者: 37度 时间: 2009-12-31 18:22
临床表现:急性病程,查痰结核菌阴性。
影像所见:右上肺见一巨大厚壁空洞,内壁欠光整,右上肺广泛斑片状、大片状模糊阴影。
抗炎治疗10天后复查:右上肺模糊阴影明显减少。
诊断意见:考虑右上肺巨大含气囊肿并感染,建议继续治疗后复查。
不支持点:空腔壁较厚,欠光滑。询问病人是否有反复感染病史?
结核临床及影像,结核暂不考虑。
作者: 吴医师 时间: 2009-12-31 18:50
标题: 回复:ct23873:男,70,发烧咳嗽咳痰10余天,查痰结核菌阴性
以下是引用wufeisheng在2009-12-31 0:32:00的发言:[br]临床表现:急性病程,查痰结核菌阴性。[br]影像所见:右上肺见一巨大厚壁空洞,内壁欠光整,右上肺广泛斑片状、大片状模糊阴影。[br]抗炎治疗10天后复查:右上肺模糊阴影明显减少。[br]诊断意见:考虑右上肺巨大含气囊肿并感染,建议继续治疗后复查。[br]不支持点:空腔壁较厚,欠光滑。询问病人是否有反复感染病史?[br]结核临床及影像,结核暂不考虑。[br]
作者: 深泽交通 时间: 2009-12-31 18:59
考虑肺囊肿伴感染
| 欢迎光临 医影在线 (http://bbs.radida.com/bbs/) |
Powered by Discuz! X3.2 |